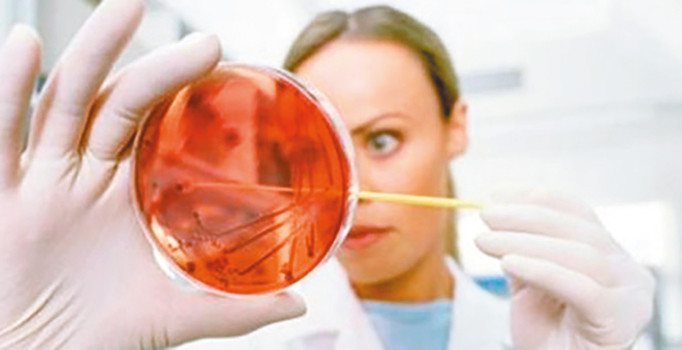
Hepatiti yalnızca temizlik önler

Hastaları karaciğer yetmezliğinden ölüme sürükleyen ve büyük acılara sebep olan hepatit, uzmanlara göre çağın vebası. Dünya Sağlık Örgütü’nün 2017 verilerinde şu an 325 milyon kişinin hepatit hastası olduğu belirtiliyor. Dünya Hepatit Farkındalık Günü’ne yönelik açıklamalarda bulunan doktorlar bu sinsi hastalığın önüne geçmek için her türlü hijyen koşuluna dikkat edilmesini tavsiye ediyor. Yakın Doğu Üniversitesi Hastanesi Enfeksiyon Hastalıkları ve Klinik Mikrobiyoloji Anabilim Dalı Uzmanı Doç. Dr. Kaya Süer, karaciğer iltihabı olan ve pek çok nedene bağlı gelişen hepatit hastalığının başlıca nedenleri arasında viral infeksiyonların geldiğini, viral hepatitlere sebep olan farklı virus tiplerinin A, B, C, D ve E tipi virüsler olduğunu, ayrıca diğer etken patojenlerin de hepatite sebep olabildiğini ifade etti. Süer, 2016 yılı verilerinde ise 1.4 milyon kişinin bu hastalıklardan hayatını kaybettiğini belirtti.
Hepatit B ile Hepatit C’nin neden olduğu ve karaciğerde oluşan siroz ile karaciğer kanseri gibi durumların ölüm nedeni olarak araştırmalarda gösterildiğini söyleyen Süer, bulaşıcı yolları olarak riskli davranışları da şöyle sıraladı: “Kontrol edilmemiş kan transfüzyonu ya da kan ürünlerinin kullanımı, sterilize edilmemiş araçlarla tıbbi ya da diş girişimleri, doğum sırasında anneden bebeğe geçiş, kullanılmış enjektör paylaşımı, tıraş bıçağı, diş fırçası gibi eşyaların paylaşımı, sterilize edilmemiş araçlarla dövme ya da vücut takıları uygulanması, güvenli olmayan cinsel ilişki.” Hepatit B virüsünden korunmanın en etkili yolunun aşı olduğunu söyleyen Süer, global olarak 2015 yılından itibaren yeni doğan çocukların en az yüzde 84’üne üç doz Hepatit B aşısı uygulandığını belirtti. Bu nedenle dünya genelinde 5 yaş altı çocuklarda Hepatit B hastalığının görülme riskinin çok düşük olduğunu söyleyen Süer, aşı öncesi dönemde enfekte olan 257 milyon erişkin kronik Hepatit B hastasının halen yaşamlarını sürdürdüğünü ifade etti.